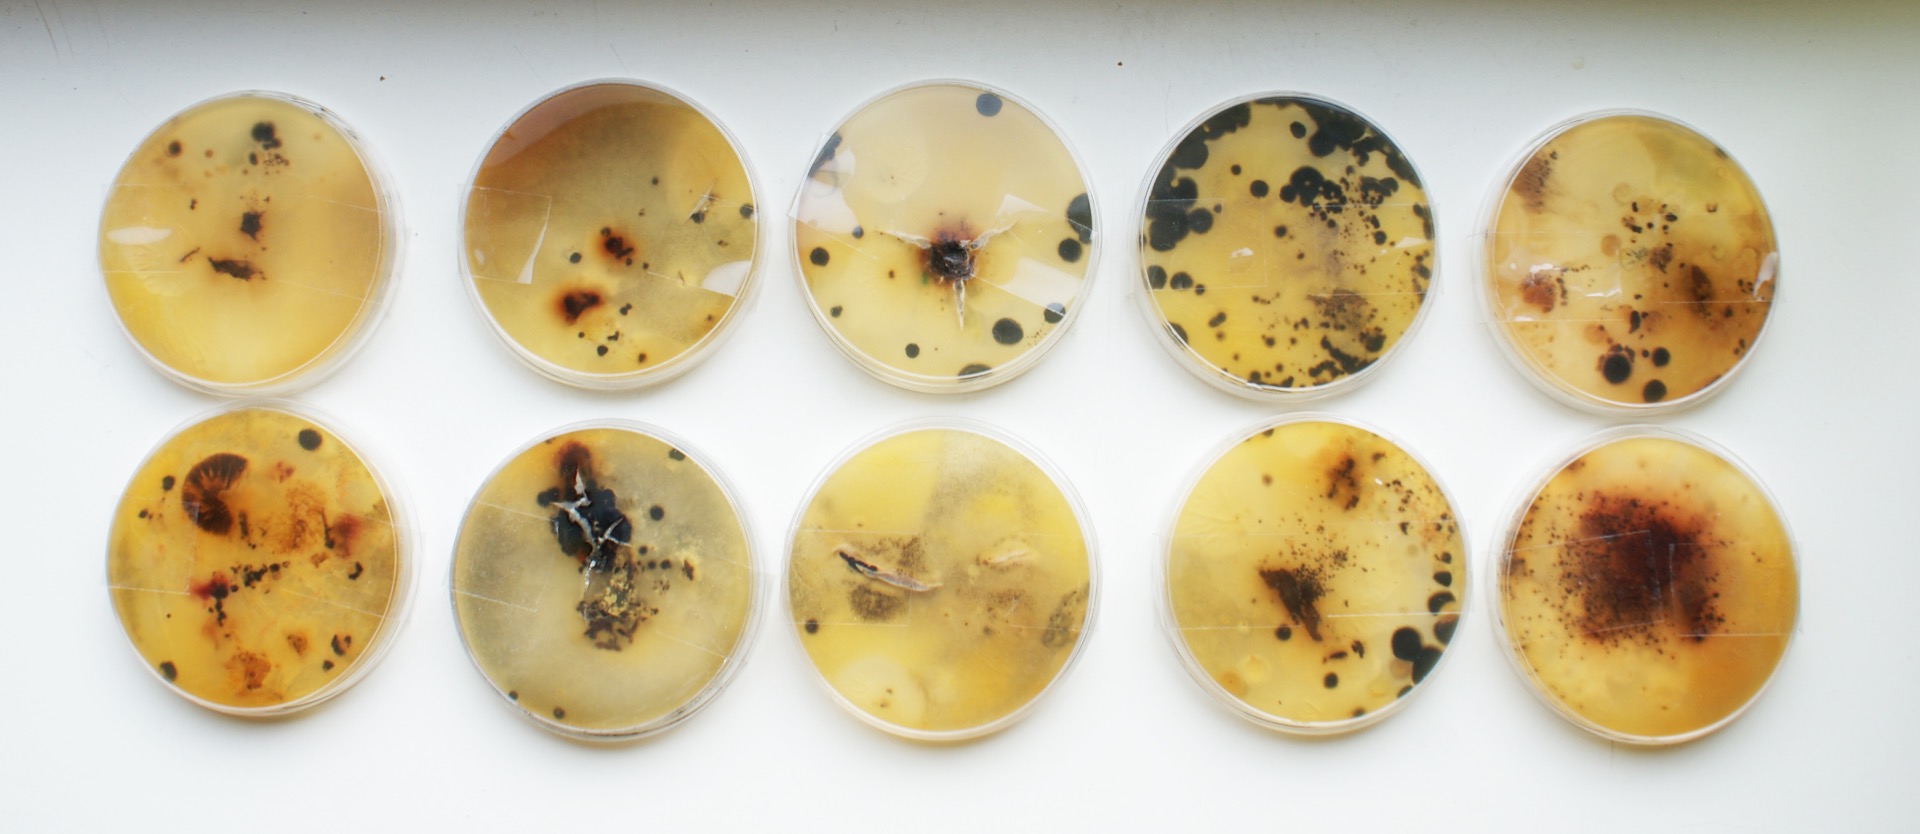

WORK
Roots Collective's Fungi Narratives
Artistic research on the role Fungi take in our ecosystem (2022 - ongoing)
To discover the role fungi can play in regenerative making designers Jesse Greulich and Lotte Gulpers of Roots Collective took a closer look at all fungal organisms in Amstelpark. For six weeks the mushrooms and parts of the underground entangled life were observed, documented, and mapped.
Fungi Narratives was a part of The School for Multispecies Knowledges. The installation was on show at De Orangerie, Zone2source June 2 - 3, 2022. Alongside The Fungi Narratives, observational prompts could be followed to foster regenerative and reciprocal habits.
Swart Laeken
Material driven garments (2019)
The iconic black wool fabric from the 17th century's Dutch paintings serves as an inspiration for research into a historic craft that almost completely disappeared from the Netherlands. Link to video
The handwoven garments of Swart Laeken are designed to show and rethink the properties of an iconic fabric, made from local Zwartbles wool, dyed with organic indigo, and lined with linen. Swart Laeken is a materialized need for high-quality garments, crafted with care, that will last a lifetime.
Interface DesignLab Young talent
Research on mono-material recycling (2019)
Interface, a manufacturer of carpet tiles, is committed to sustainability and circularity, under the motto «Positive for People and Planet». Link to exhibition video
As part of the Interface DesignLaB Young Talent project, the designers Lotte Gulpers and Lena Winterink did material studies. They also provide a clear overview of how a carpet tile is constructed from different layers. Their installation shows how Interface makes that process and the final product more sustainable and more circular step by step. Leonne Cuppen supervised this cross-fertilization between industry and design talents.
Photos by Oscar Vinck
Auto Seĝo
Costume design for performance art (2017)
The world is changing rapidly. The economical governmental and democratic systems are in crisis. Powers are shifting and we have to develop new relations and values among people, people as objects, players, and spectators. This complexity calls for a new framework, a direct approach to the human body.
The world needs a new system that produces zero waste and helps maintain a healthy and interesting lifestyle. A new sport has aroused to answer these needs. This sport has no boundaries and it creates no waste or matters it questions only muscles. Auto Seĝo! Link to video
